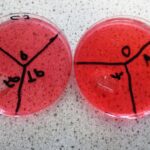

Curriculum
Science
“Science is the process that takes us from confusion to understanding.” Brian Greene
Exam board: AQA
Qualification: GCSE Combined Science: Synergy
Our philosophy: Science for all – We believe that Science has something to offer for every pupil. That is why all our pupils study Biology, Chemistry and Physics tailored to suit pupils of all abilities and all aspirations. This also keeps their options open for their re-integration into mainstream schools.
Year 10 and 11 pupils study the AQA Combined Science (Synergy) curriculum, allowing everyone to secure a double GCSE Science qualification. The core theory content follows a coherent and logical story through the three sciences and is linked to several required practical activities, which develop understanding through hands-on experience